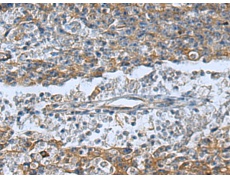
一抗

中文名稱:兔抗BMF多克隆抗體
|
Background: |
The protein encoded by this gene belongs to the BCL2 protein family. BCL2 family members form hetero- or homodimers and act as anti- or pro-apoptotic regulators that are involved in a wide variety of cellular activities. This protein contains a single BCL2 homology domain 3 (BH3), and has been shown to bind BCL2 proteins and function as an apoptotic activator. This protein is found to be sequestered to myosin V motors by its association with dynein light chain 2, which may be important for sensing intracellular damage and triggering apoptosis. Alternatively spliced transcript variants encoding different isoforms have been identified. |
|
Applications: |
ELISA, WB, IHC |
|
Name of antibody: |
BMF |
|
Immunogen: |
Synthetic peptide of human BMF |
|
Full name: |
Bcl2 modifying factor |
|
SwissProt: |
Q96LC9 |
|
ELISA Recommended dilution: |
5000-10000 |
|
IHC positive control: |
Human liver cancer and Human gastric cancer |
|
IHC Recommend dilution: |
50-200 |
|
WB Predicted band size: |
20 kDa |
|
WB Positive control: |
293T cell lysate |
|
WB Recommended dilution: |
500-2000 |



 購物車
購物車 幫助
幫助
 021-54845833/15800441009
021-54845833/15800441009